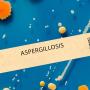
Pilzinfektion Aspergillose

Pseudomonas aeruginosa ist ein Bakterium, das besonders anspruchslos gegenüber seinen Lebensbedingungen ist. Es ist einer der häufigsten Erreger von nosokomialen Infektionen und gegen viele Antibiotika resistent.

Nosokomiale Infektionen passieren im Zuge stationärer oder ambulanter medizinischer Maßnahmen und basieren oft auf eher harmlosen Bakterien, die aber für bestimmte Patient:innen gefährlich werden können. Oft werden diese Erkrankungen als Infektionen mit Krankenhauskeimen bezeichnet.5 Pseudomonas aeruginosa überlebt sowohl in trockener als auch feuchter Umgebung. Das natürliche Lebensumfeld von P. aeruginosa sind Feuchtgebiete in der Umwelt; der Erreger ist aber auch in Kliniken zu finden.1 In Krankenhäusern kommt es zum Beispiel in Beatmungsschläuchen, Luftbefeuchtern, Waschbecken, Blumenvasen oder zentralen Desinfektionsmitteldosieranlagen vor. Es kann Entzündungen auslösen und zählt daher zu den gefährlichen Krankenhauskeimen. Infektionen mit Pseudomonas aeruginosa werden durch eine geschwächte Immunabwehr begünstigt.4
Gefahr bei schwachem Immunsystem
Pseudomonas aeruginosa zählt weltweit zu den häufigsten Ursachen von nosokomialen Lungenentzündungen bei Beatmung, Wund- und Harnwegsinfektionen; die Bakterien können auch eine Blutstrominfektion (Sepsis) auslösen. In erster Linie sind immunsupprimierte Patient:innen betroffen, also solche mit einem geschwächten Immunsystem. Nosokomiale Lungenentzündung und Sepsis sind mit einer hohen Sterblichkeit verbunden. Die Betroffenen infizieren sich in erster Linie durch Kontakt mit dem Erreger in der Umwelt. Innerhalb von Kliniken kommen auch Übertragungen von Patient:in zu Patient:in, zum Beispiel über die Hände des Pflegepersonals, vor. Die meisten P. aeruginosa-Stämme sind von Natur aus gegen eine Vielzahl von Antibiotika resistent.1
Pseudomonas aeruginosa stellt zum Beispiel für Mukoviszidose-Patient:innen ein großes Risiko dar2, aber auch COPD-Patient:innen oder Patient:innen auf einer Intensivstation gelten als besonders gefährdet.4 Im Laufe ihres Lebens erwerben die meisten Mukoviszidose-Patient:innen als häufigste Komplikation eine Besiedlung oder Infektion der Atemwege. Bakterielle Erreger sind neben Stapylococcus aureus und Pneumokokken auch Pseudomonas aeruginosa und andere multiresistente gramnegative Erreger.2 Sie werden als multiresistent bezeichnet, weil viele Antibiotika nicht mehr ausreichend wirksam dagegen sind. Infektionen sind daher schwer behandelbar. Ein ernstes Gesundheitsrisiko sind solche Erkrankungen vor allem für ältere und immungeschwächte Patient:innen.3
Therapie gegen multiresistenten Erreger
Pseudomonas aeruginosa bildet konstitutionell sogenannte β-Laktamasen, sodass die meisten Penicilline und Cephalosporine aufgrund von Antibiotikaresistenzen unwirksam sind. Bei Verdacht auf Infektionen mit Pseudomonas aeruginosa werden daher bestimmte Antibiotika-Kombinationen zur Therapie herangezogen und es wird nach den aktuellen Leitlinien für multiresistente gramnegative Erreger therapiert.4 An neuen Therapieoptionen gegen Pseudomonas aeruginosa wird intensiv geforscht.
2391/TCP/MehrLuftTexte/AT/04-2024
Quellen:
1) https://www.rki.de/DE/Content/Infekt/Antibiotikaresistenz/nosokomiale_Erreger/Pseudomonas.html
3) https://www.rki.de/DE/Content/Institut/OrgEinheiten/Abt1/FG13/mutiresistente_gram_neg_Erreger.html
4) https://flexikon.doccheck.com/de/Pseudomonas_aeruginosa
5) https://www.gesundheit.gv.at/lexikon/N/nosokomiale-infektionen-hk.html